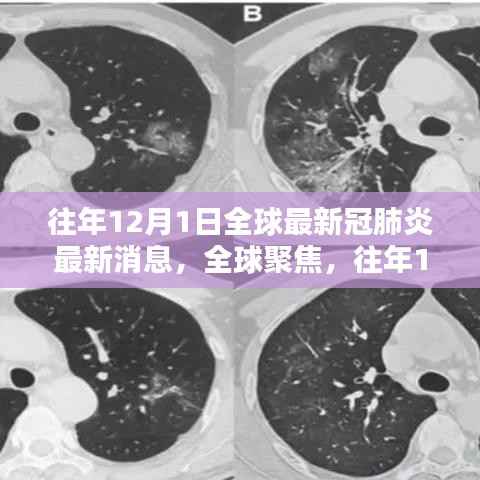
全球聚焦，往年12月1日新冠肺炎最新消息综述与观点阐述

自贡美景探秘,历史上的美好瞬间与自然的共舞旅程(12月1日)
自贡探秘之旅:追寻自然美景,拥抱内心的宁静与喜悦当时间的指针指向每年的12月1日,自贡这座美丽的城市便迎来了无数令人振奋的消息和事件,让我们一同回溯历史的长河,探寻那些关于自然美景的旅行故事,感受远离尘嚣、发现内心平...
巩义新闻热点深度解析,历史脉络下的历史回顾与最新动态(12月1日)
随着时钟的指针指向每年的12月1日,巩义这座古老而又充满活力的城市总能带给我们新的惊喜与新闻,本文将聚焦于这一时间节点上的巩义新闻热点,结合历史背景,深入分析其内在价值及影响,同时阐述个人观点和看法,希望通过本文的论...
全球聚焦,往年12月1日新冠肺炎最新消息综述与观点阐述
随着新冠疫情的蔓延,每年的全球新冠肺炎最新消息发布都牵动着亿万人的心,在往年12月1日的全球疫情通报会上,关于新冠病毒的最新消息无疑成为公众关注的焦点,本文将围绕这一话题展开论述,探讨不同观点,并阐述作者的立场及理由...
12月1日黄陂司机热门招聘信息汇总,行业分析与求职指南
随着冬季的到来,不少行业开始积极招聘人才以应对年末高峰,特别是在物流运输领域,司机岗位的需求愈加旺盛,本文将重点关注“黄陂地区”的司机招聘信息,结合当前市场趋势,为求职者提供详尽的行业分析以及求职指南,让我们一起探索...
2024年高中数学课程标准预测,新变化与挑战,把握未来数学纪元
随着时代的变迁,我们即将迈入崭新的教育纪元,站在这个充满机遇与挑战的十字路口,我们不禁对即将到来的2024年高中数学课程标准充满期待,让我们一起探讨这一未来的变革,看看它如何激发我们的潜能,让我们在学习的道路上自信闪...
12月张家口最新楼盘价格探析,市场走势与个人决策指南
随着季节的更迭,房地产市场也迎来了新的变化,张家口的房价与楼盘价格成为众多购房者关注的焦点,本文将围绕“12月张家口房价最新楼盘价格”这一主题,探讨当前市场状况,并阐述个人观点与立场。市场概况随着全球经济的复苏和国内...
历年12月1日惠安热门房价回顾与变迁影响
在时间的洪流中,惠安的房价如同波澜壮阔的画卷,不断演绎着城市发展的故事,每年的12月1日,作为这一年的重要节点,惠安的房价走势更是引人注目,本文将从背景介绍出发,回顾历年这一日期惠安热门房价的重要事件、影响,及其在特...
往年12月1日生活垃圾管理规定的解读与更新概览
随着城市化进程的加速和人民生活水平的提高,生活垃圾处理成为城市管理的重要组成部分,为了更有效地进行生活垃圾的管理和处理,我国各大城市纷纷出台新的生活垃圾管理规定,本文旨在解读往年12月1日实施的生活垃圾管理最新规定,...
成都区域划分图更新,新篇章下的友情与陪伴之旅
阳光透过薄雾,轻轻洒在了成都的新区域划分图上,随着2024年12月1日的到来,成都的新一轮区域调整正式拉开帷幕,而这一天,对于主人公小杨和他的好友们来说,更像是一个温馨故事的开端。小杨是个土生土长的成都人,从小在这座...
揭秘隐藏版特色小店,官场热门新宠的非凡魅力与小巷深处的秘密故事
在繁华都市的喧嚣中,总有一些意想不到的惊喜藏匿于寻常巷陌,就在最近的官场热门话题中,一家隐藏在小巷深处的特色小店意外走红,成为了都市人们争相探访的新宠,就让我们一起走进这家神秘的小店,探寻它的独特魅力吧!小巷深处的秘...

蜀ICP备2022005971号-1
蜀ICP备2022005971号-1